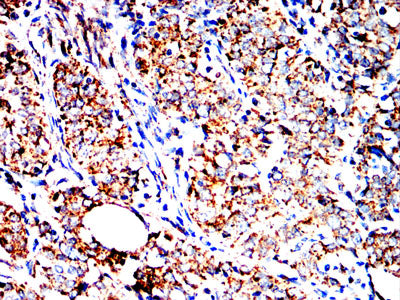
产品细节图片7

相关产品推荐更多 >
万千商家帮你免费找货
0 人在求购买到急需产品
- 详细信息
- 文献和实验
- 技术资料
- 免疫原:
Purified recombinant fragment of human HSPA9 (AA: 480-679) expressed in mammalian.
- 形态:
liquid
- 保存条件:
Store at -20˚C
- 克隆性:
Monoclonal
- 适应物种:
Human,Mouse,Monkey,Rat
- 保质期:
12 months
- 抗原来源:
Mouse
- 供应商:
南京赛戈巍生物科技有限公司
- 宿主:
Mouse
- 应用范围:
WB;IHC;IF;FC
- 靶点:
Uniprot:P38646
- 抗体英文名:
HSPA9 Mouse mAb
- 规格:
50ul/100ul
计算分子量:74KDa
配方:Purified antibody in PBS with 0.05% sodium azide
应用详情:WB:1/500 - 1/2000
IHC:1/200 - 1/1000
ICC:1/200 - 1/1000
FC:1/200 - 1/400
ELISA:1/10000
图片:

Black line: Control Antigen (100 ng);Purple line: Antigen (10ng); Blue line: Antigen (50 ng); Red line:Antigen (100 ng)
,

Western blot analysis using HSPA9 mouse mAb against A549 (1), PANC-1 (2), PC-12 (3), C6 (4), CSO-7 (5)and NIH3T3 (6) cell lysate.
,

Immunofluorescence analysis of Hela cells using HSPA9 mouse mAb (green). Blue: DRAQ5 fluorescent DNA dye. Red: Actin filaments have been labeled with Alexa Fluor- 555 phalloidin. Secondary antibody from Fisher (Cat#: 35503)
,

Flow cytometric analysis of Hela cells using HSPA9 mouse mAb (green) and negative control (red).
,

Flow cytometric analysis of Jurkat cells using HSPA9 mouse mAb (green) and negative control (red).
,

Flow cytometric analysis of HepG2 cells using HSPA9 mouse mAb (green) and negative control (red).
,
Immunohistochemical analysis of paraffin-embedded human cervical carcinoma tissues using HSPA9 mouse mAb with DAB staining.
,

Immunohistochemical analysis of paraffin-embedded human rectal cancer tissues using HSPA9 mouse mAb with DAB staining.
风险提示:丁香通仅作为第三方平台,为商家信息发布提供平台空间。用户咨询产品时请注意保护个人信息及财产安全,合理判断,谨慎选购商品,商家和用户对交易行为负责。对于医疗器械类产品,请先查证核实企业经营资质和医疗器械产品注册证情况。
文献和实验(adjust pH to 7.8 with Binding buffer; red color) to the Protein A column.Mouse antibodies of the IgG1 subclass do not have a high affinity for protein A. Purification on protein A beads using standard conditions will yield approximately 1/10
Purification of mAb (IgG) by Chang-Duk Jun, 03/14/2000 Purpose Materials Antibody 7E3 , 2L sup grown in flasks, frozen and thawed overnight. BioRad Affi-Gel Protein A MAPS II Buffers
T-Cell Activation Using mAb to CD3
One of the most common ways to assess T cell activation is to measure T cell proliferation upon in vitro stimulation of T cells via antigen or agonistic antibodies to TCR. This protocol is written as a starting point for examining in vitro proliferation of mouse
技术资料暂无技术资料 索取技术资料





![SCGB1A1 Rabbit mAb[49757]](https://img1.dxycdn.com/p/s14/2025/0923/278/4431488150116040791.jpg!wh200)
![ALKBH7 Antibody[45690]](https://img1.dxycdn.com/p/s14/2025/0922/568/0046652811090600791.jpg!wh200)
![PLEKHF2 Polyclonal Antibody[30980]](https://img1.dxycdn.com/p/s14/2025/0923/305/2150219664296040791.jpg!wh200)
